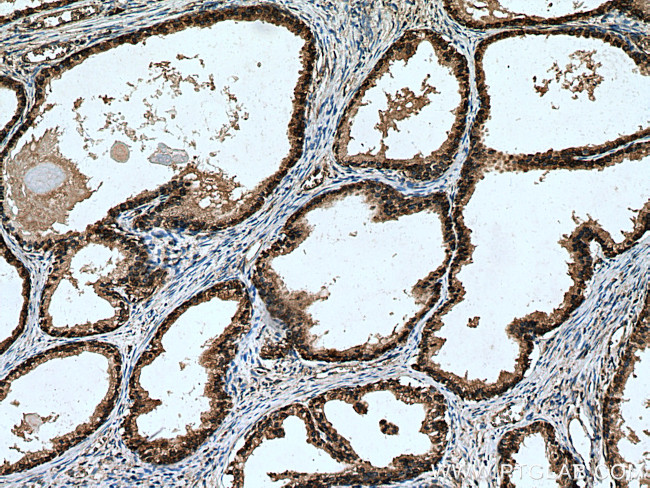
RPL5 Antibody in Immunohistochemistry (Paraffin) (IHC (P))

Search
Proteintech
RPL5 Polyclonal Antibody
{{$productOrderCtrl.translations['antibody.pdp.commerceCard.promotion.promotions']}}
{{$productOrderCtrl.translations['antibody.pdp.commerceCard.promotion.viewpromo']}}
{{$productOrderCtrl.translations['antibody.pdp.commerceCard.promotion.promocode']}}: {{promo.promoCode}} {{promo.promoTitle}} {{promo.promoDescription}}. {{$productOrderCtrl.translations['antibody.pdp.commerceCard.promotion.learnmore']}}
产品信息
29092-1-AP
种属反应
宿主/亚型
分类
类型
抗原
偶联物
形式
浓度
规格
纯化类型
保存液
内含物
保存条件
运输条件
产品详细信息
Aliquoting is unnecessary for -20°C storage.
靶标信息
RPL5 encodes a ribosomal protein that is a component of the 60S subunit. The protein belongs to the L18P family of ribosomal proteins. It is located in the cytoplasm. The protein binds 5S rRNA to form a stable complex called the 5S ribonucleoprotein particle (RNP), which is necessary for the transport of nonribosome-associated cytoplasmic 5S rRNA to the nucleolus for assembly into ribosomes. The protein interacts specifically with the beta subunit of casein kinase II.
仅用于科研。不用于诊断过程。未经明确授权不得转售。
生物信息学
蛋白别名: 60S ribosomal protein L5; Large ribosomal subunit protein uL18; protein phosphatase 1, regulatory subunit 135; similar to ribosomal protein L5; unnamed protein product
基因别名: L5; MSTP030; PPP1R135; RPL5; uL18
UniProt ID: (Human) P46777
Entrez Gene ID: (Human) 6125